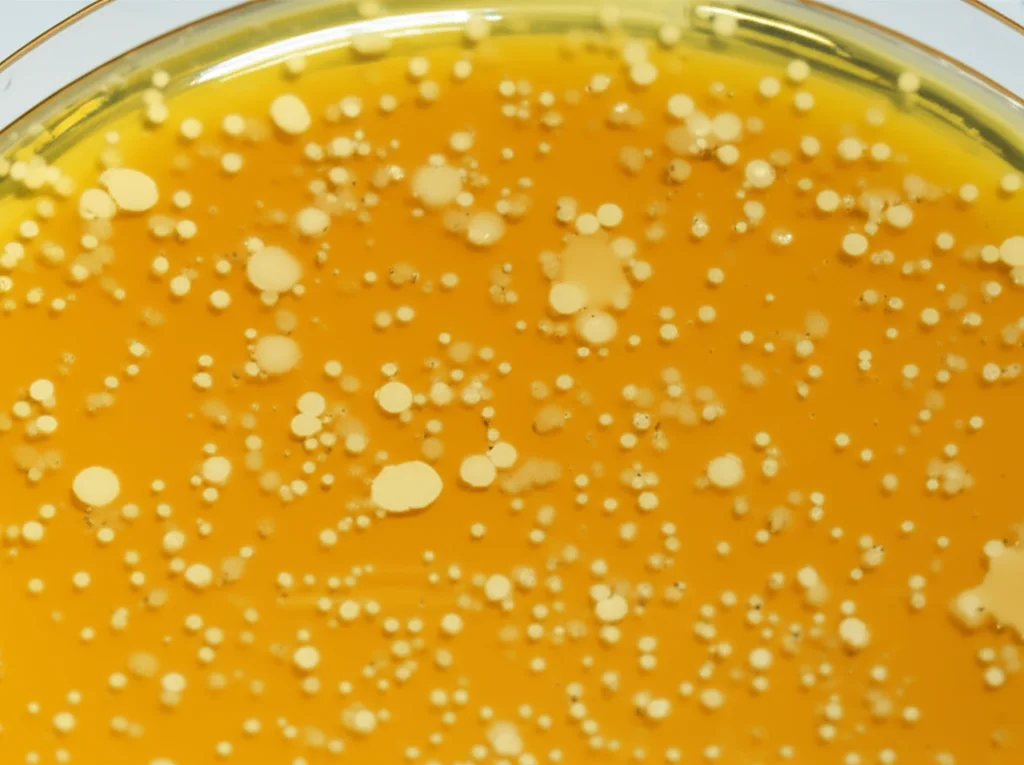
Immagine macro di una piastra di Petri con colture cellulari, alcune cellule mostrano l'effetto citopatico virale (arrotondamento, distacco), illuminazione da laboratorio precisa e controllata, obiettivo macro 60mm, alta definizione.

Herpesvirus Felino Nascosto? Ecco Come lo Stanliamo Anche Quando il Calicivirus Fa il Prepotente!
Ciao a tutti, amanti dei nostri amici felini! Oggi voglio raccontarvi una storia che arriva dritta dritta dal mondo della ricerca veterinaria, una di quelle sfide che ci tengono svegli la notte, ma che poi, quando trovi la soluzione, ti danno una soddisfazione pazzesca. Parliamo di mici, di starnuti, di occhietti che lacrimano e, soprattutto, di due virus un po’ dispettosi: l’Herpesvirus felino 1 (FHV-1) e il Calicivirus felino (FCV).
La “Coppia Terribile” delle Infezioni Respiratorie Feline
Sicuramente molti di voi avranno sentito parlare, o purtroppo sperimentato, la cosiddetta “malattia respiratoria complessa felina” (FRDC), quella che comunemente chiamiamo “il raffreddore del gatto”. Ecco, FHV-1 e FCV sono i principali colpevoli. Sono diffusissimi in tutto il mondo e, come se non bastasse, amano fare “squadra”. Le co-infezioni, cioè la presenza di entrambi i virus contemporaneamente, sono frequentissime nei gatti con problemi respiratori, specialmente in ambienti affollati come gattili o colonie, dove lo stress gioca un ruolo non da poco. Pensate che la FRDC è la seconda causa di eutanasia nei rifugi dopo il sovraffollamento!
L’FHV-1 di solito si manifesta con rinite e congiuntivite, quindi starnuti a raffica, scolo nasale e oculare, a volte accompagnati da febbre, perdita di appetito e un generale abbattimento. L’FCV, invece, è più tipicamente associato a ulcerazioni in bocca, magari con sintomi respiratori e congiuntivali più lievi. Il problema è che, quando ci sono entrambi, la diagnosi e soprattutto lo studio specifico di uno dei due diventa un vero rompicapo.
Il Problema dell’Isolamento: L’FHV-1, il Timido della Coppia
Noi ricercatori, per capire bene un patogeno, abbiamo bisogno di isolarlo in laboratorio, farlo crescere in colture cellulari per studiarne le caratteristiche. Ma quando FHV-1 e FCV sono insieme nello stesso campione, isolare l’FHV-1 “puro” con i metodi tradizionali è un’impresa ardua. Perché? Beh, l’FCV è un tipo piuttosto invadente e veloce: si replica rapidamente nelle cellule e produce un effetto citopatico (cioè un danno visibile alle cellule) molto presto. L’FHV-1, al contrario, è un po’ più “lento” e discreto. Risultato? L’FCV prende il sopravvento, mascherando o addirittura impedendo la crescita dell’FHV-1.
Questo è un bel guaio, perché se non riusciamo a isolare l’FHV-1, facciamo fatica a capire la sua reale diffusione, le sue varianti, come risponde ai farmaci… Insomma, tutta l’indagine epidemiologica ne risente. Addirittura, a volte, anche se l’FHV-1 c’è, dopo qualche passaggio in coltura scompare, “mangiato” dalla crescita più vigorosa dell’FCV. Immaginate di cercare un fiore raro in un campo invaso da erbacce infestanti: una faticaccia!
La Nostra Idea: Neutralizzare il “Bullo” per Far Emergere il “Timido”
Di fronte a questa difficoltà, ci siamo chiesti: e se potessimo “neutralizzare” l’FCV, metterlo temporaneamente fuori gioco per dare all’FHV-1 la possibilità di crescere e farsi vedere? Da qui è partita la nostra avventura. L’idea era quella di usare il metodo della neutralizzazione virale. In pratica, si tratta di utilizzare degli anticorpi specifici contro l’FCV per bloccarlo.
Come abbiamo fatto?
- Abbiamo immunizzato dei conigli con il virus FCV (isolato precedentemente nel nostro laboratorio). In parole povere, abbiamo “presentato” il virus al sistema immunitario dei conigli, che hanno così prodotto degli anticorpi policlonali specifici contro l’FCV.
- Abbiamo prelevato il siero da questi conigli, ricco di questi anticorpi “anti-FCV”. Abbiamo verificato la loro efficacia, e i titoli anticorpali (cioè la loro “potenza”) erano ottimi, specialmente dopo 60 giorni dalla prima immunizzazione.
- A questo punto, abbiamo preso i campioni biologici dei gatti che sapevamo essere co-infetti da FHV-1 e FCV e li abbiamo trattati con questo siero. L’obiettivo era che gli anticorpi si legassero all’FCV, impedendogli di infettare le cellule in coltura.
Dopo questo pre-trattamento, abbiamo proceduto con il normale isolamento virale su colture cellulari (cellule CRFK, ovvero rene di gatto, che sono un terreno di coltura standard per questi virus).
I Risultati: Missione Compiuta!
Ebbene sì, ha funzionato! Dopo diversi “round” di neutralizzazione, siamo finalmente riusciti a ottenere l’FHV-1 in forma pura! Inizialmente, quando mettevamo in coltura i campioni non trattati, già dopo 6-24 ore vedevamo i segni tipici dell’infezione da FCV: cellule che diventavano tonde, si raggrinzivano, si aggregavano. L’FHV-1, se c’era, si vedeva a malapena con le tecniche di immunofluorescenza (che usano anticorpi marcati con coloranti fluorescenti per “illuminare” i virus).
Ma dopo il trattamento con gli anticorpi anti-FCV, la storia è cambiata. Nelle colture cellulari inoculate con i campioni trattati, l’effetto citopatico tipico dell’FCV era scomparso o fortemente ridotto. Invece, con il passare delle ore (da 6 a 24), iniziavano a manifestarsi i segni caratteristici dell’infezione da FHV-1: cellule arrotondate, picnosi (restringimento del nucleo), e una degenerazione del monostrato cellulare che a volte ricorda un “vello di pecora”. L’immunofluorescenza ce lo ha confermato: segnali verdi brillanti per l’FHV-1 e segnali rossi per l’FCV (che erano quasi assenti o molto deboli).
Per essere ancora più sicuri, abbiamo usato la QRT-PCR, una tecnica molecolare super sensibile che permette non solo di rilevare la presenza del virus, ma anche di quantificarlo. I risultati sono stati chiari: con l’aumentare dei cicli di neutralizzazione, la quantità di FHV-1 aumentava progressivamente, mentre quella di FCV diminuiva drasticamente, fino a scomparire. Abbiamo così isolato con successo 4 ceppi di FHV-1 da campioni co-infetti!
Perché Questo Metodo è Così Importante?
Qualcuno potrebbe dire: “Ok, bello, ma a che serve?”. Serve, e come!
- Migliora la diagnosi: poter isolare l’FHV-1 ci permette di confermare la sua presenza e di non sottostimare la sua incidenza.
- Facilita la ricerca epidemiologica: possiamo studiare meglio la diffusione dell’FHV-1, identificare le varianti circolanti, capire come si evolve.
- Sviluppo di vaccini e terapie: avere ceppi puri di FHV-1 è fondamentale per testare l’efficacia di nuovi vaccini o farmaci antivirali.
- Applicabilità ad altre situazioni: in teoria, questo metodo potrebbe essere adattato per isolare altri virus “timidi” in presenza di co-infezioni con virus più aggressivi, o per purificare campioni contaminati.
Prima di questo studio, si pensava spesso che nei campioni co-infetti l’FHV-1 potesse non esprimersi affatto a causa dell’inibizione da parte dell’FCV. Noi abbiamo dimostrato che l’FHV-1 si esprime eccome, ma la rapida azione dell’FCV ne limita la manifestazione visibile in coltura.
Certo, il metodo ha qualche limite. Gli anticorpi policlonali che abbiamo prodotto, essendo specifici per un ceppo di FCV di laboratorio, potrebbero non essere efficaci al 100% contro tutti i varianti di FCV presenti “in natura”, data l’alta variabilità genetica di questo virus. Tuttavia, anche così, aumenta significativamente le probabilità di successo nell’isolare l’FHV-1, specialmente quando i campioni sono preziosi e limitati. L’ottimizzazione della concentrazione degli anticorpi e del rapporto di miscelazione potrebbe ulteriormente accorciare i tempi di purificazione, ma questo richiederà ulteriori esplorazioni.
Un Piccolo Passo per il Laboratorio, un Grande Passo per i Nostri Mici
Insomma, con un po’ di ingegno e perseveranza, siamo riusciti a trovare un modo efficace per “smascherare” l’Herpesvirus felino anche quando si nasconde dietro al suo “collega” più esuberante, il Calicivirus. È una piccola vittoria nel grande campo della ricerca virologica, ma speriamo possa fornire uno strumento utile a molti colleghi e, in ultima analisi, contribuire a migliorare la salute e il benessere dei nostri adorati gatti. La prossima volta che vedrete il vostro micio starnutire, pensate che dietro a quel semplice sintomo potrebbe nascondersi una complessa interazione virale che noi scienziati stiamo cercando, passo dopo passo, di decifrare!
Fonte: Springer
